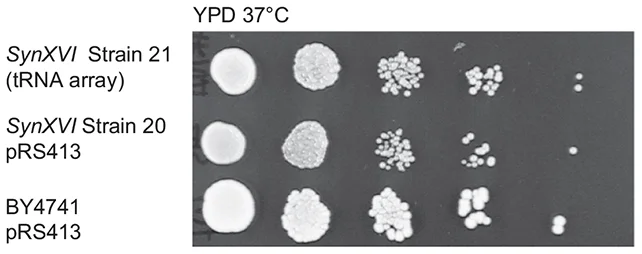

Ученые достигли важной вехи в создании синтетической жизни
После более чем десятилетней работы ученые достигли важной вехи в своих усилиях по реорганизации жизни в лаборатории, собрав последнюю хромосому в синтетическом геноме дрожжей (Saccharomyces cerevisiae).
Исследователи, возглавляемые командой из Университета Маккуори (Австралия), выбрали дрожжи, чтобы продемонстрировать потенциал производства продуктов питания, способных выжить в условиях меняющегося климата или широко распространенных болезней.
Это первый случай создания полноценного синтетического эукариотического генома, последовавший за успехами в работе с более простыми бактериальными организмами. Это доказательство того, что ученые могут синтезировать более сложные организмы, такие как пищевые культуры.
«Это знаменательный момент в синтетической биологии», — говорит молекулярный микробиолог Сакки Преториус из Университета Маккуори. «Это последний кусочек головоломки, которая занимала исследователей синтетической биологии уже много лет».
Это не означает, что мы можем начать выращивать полностью искусственные дрожжи с нуля, но это означает, что живые дрожжевые клетки потенциально могут быть полностью перекодированы — хотя для этого необходимо проделать еще много работы, чтобы доработать и масштабировать этот процесс.
И аналогия с кодированием вполне уместна, ведь исследователям пришлось потратить немало времени и усилий на отладку 16-й и последней синтетической дрожжевой хромосомы (названной SynXVI), прежде чем геном заработал так, как нужно.
Для выявления и устранения проблем в хромосоме были задействованы различные инструменты редактирования генов, в том числе основанные на CRISPR. Например, нужно было заставить дрожжи правильно использовать глицерин в качестве источника энергии при высоких температурах, что ученые хотели бы сделать для повышения жизнестойкости дрожжей.
Еще одна проблема, с которой столкнулась команда, связана с генетическими маркерами, которые используются для идентификации и отслеживания ДНК внутри генома. Оказалось, что расположение этих маркеров имеет большое значение — неправильное расположение может повлиять на поведение клеток.
«Одним из наших ключевых открытий стало то, что расположение генетических маркеров может нарушить экспрессию важных генов», — говорит биолог-синтетик Хью Гоулд из Университета Маккуори.
Проект Sc2.0, частью которого является данное исследование, направлен не только на модификацию сельскохозяйственных культур. Те же принципы можно применить к лекарствам и устойчивым к внешним воздействиям материалам, ускорив их производство или сделав их более прочными.
Наши усилия в области генной инженерии становятся все более амбициозными и всеобъемлющими, и это еще один значительный шаг на этом пути. Улучшения отчасти обусловлены достижениями в области технологий и методов, а робототехника, доступная в Australian Genome Foundry, имеет решающее значение в этом конкретном исследовании.
«Синтетический геном дрожжей представляет собой квантовый скачок в нашей способности к инженерной биологии», — говорит биолог-синтетик Бриандо Льоренте (Briardo Llorente) из Университета Маккуори. «Это достижение открывает захватывающие возможности для разработки более эффективных и устойчивых процессов биопроизводства, от производства фармацевтических препаратов до создания новых материалов».
Исследование опубликовано в журнале Nature Communications.